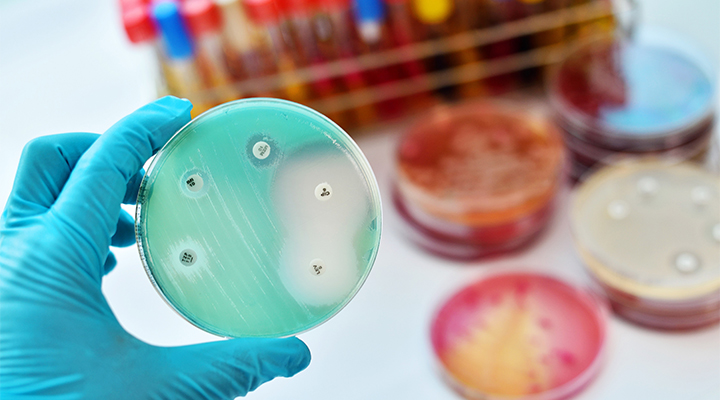
Tüketici Olarak Antimikrobiyal Direnç Hakkında Ne Bilmeliyim?

Tüketici Olarak Antimikrobiyal Direnç Hakkında Ne Bilmeliyim?
Antimikrobiyal direnç (AMR), mikroorganizmaların antibiyotikler ve diğer antimikrobiyal ilaçlara karşı direnç geliştirmesiyle ortaya çıkan ve halk sağlığını küresel düzeyde tehdit eden bir sorundur. Bu durum, daha önce kolayca tedavi edilebilen enfeksiyonların artık tedaviye yanıt vermemesi anlamına gelir. Dirençli bakterilerle gelişen...
Yazıyı Oku